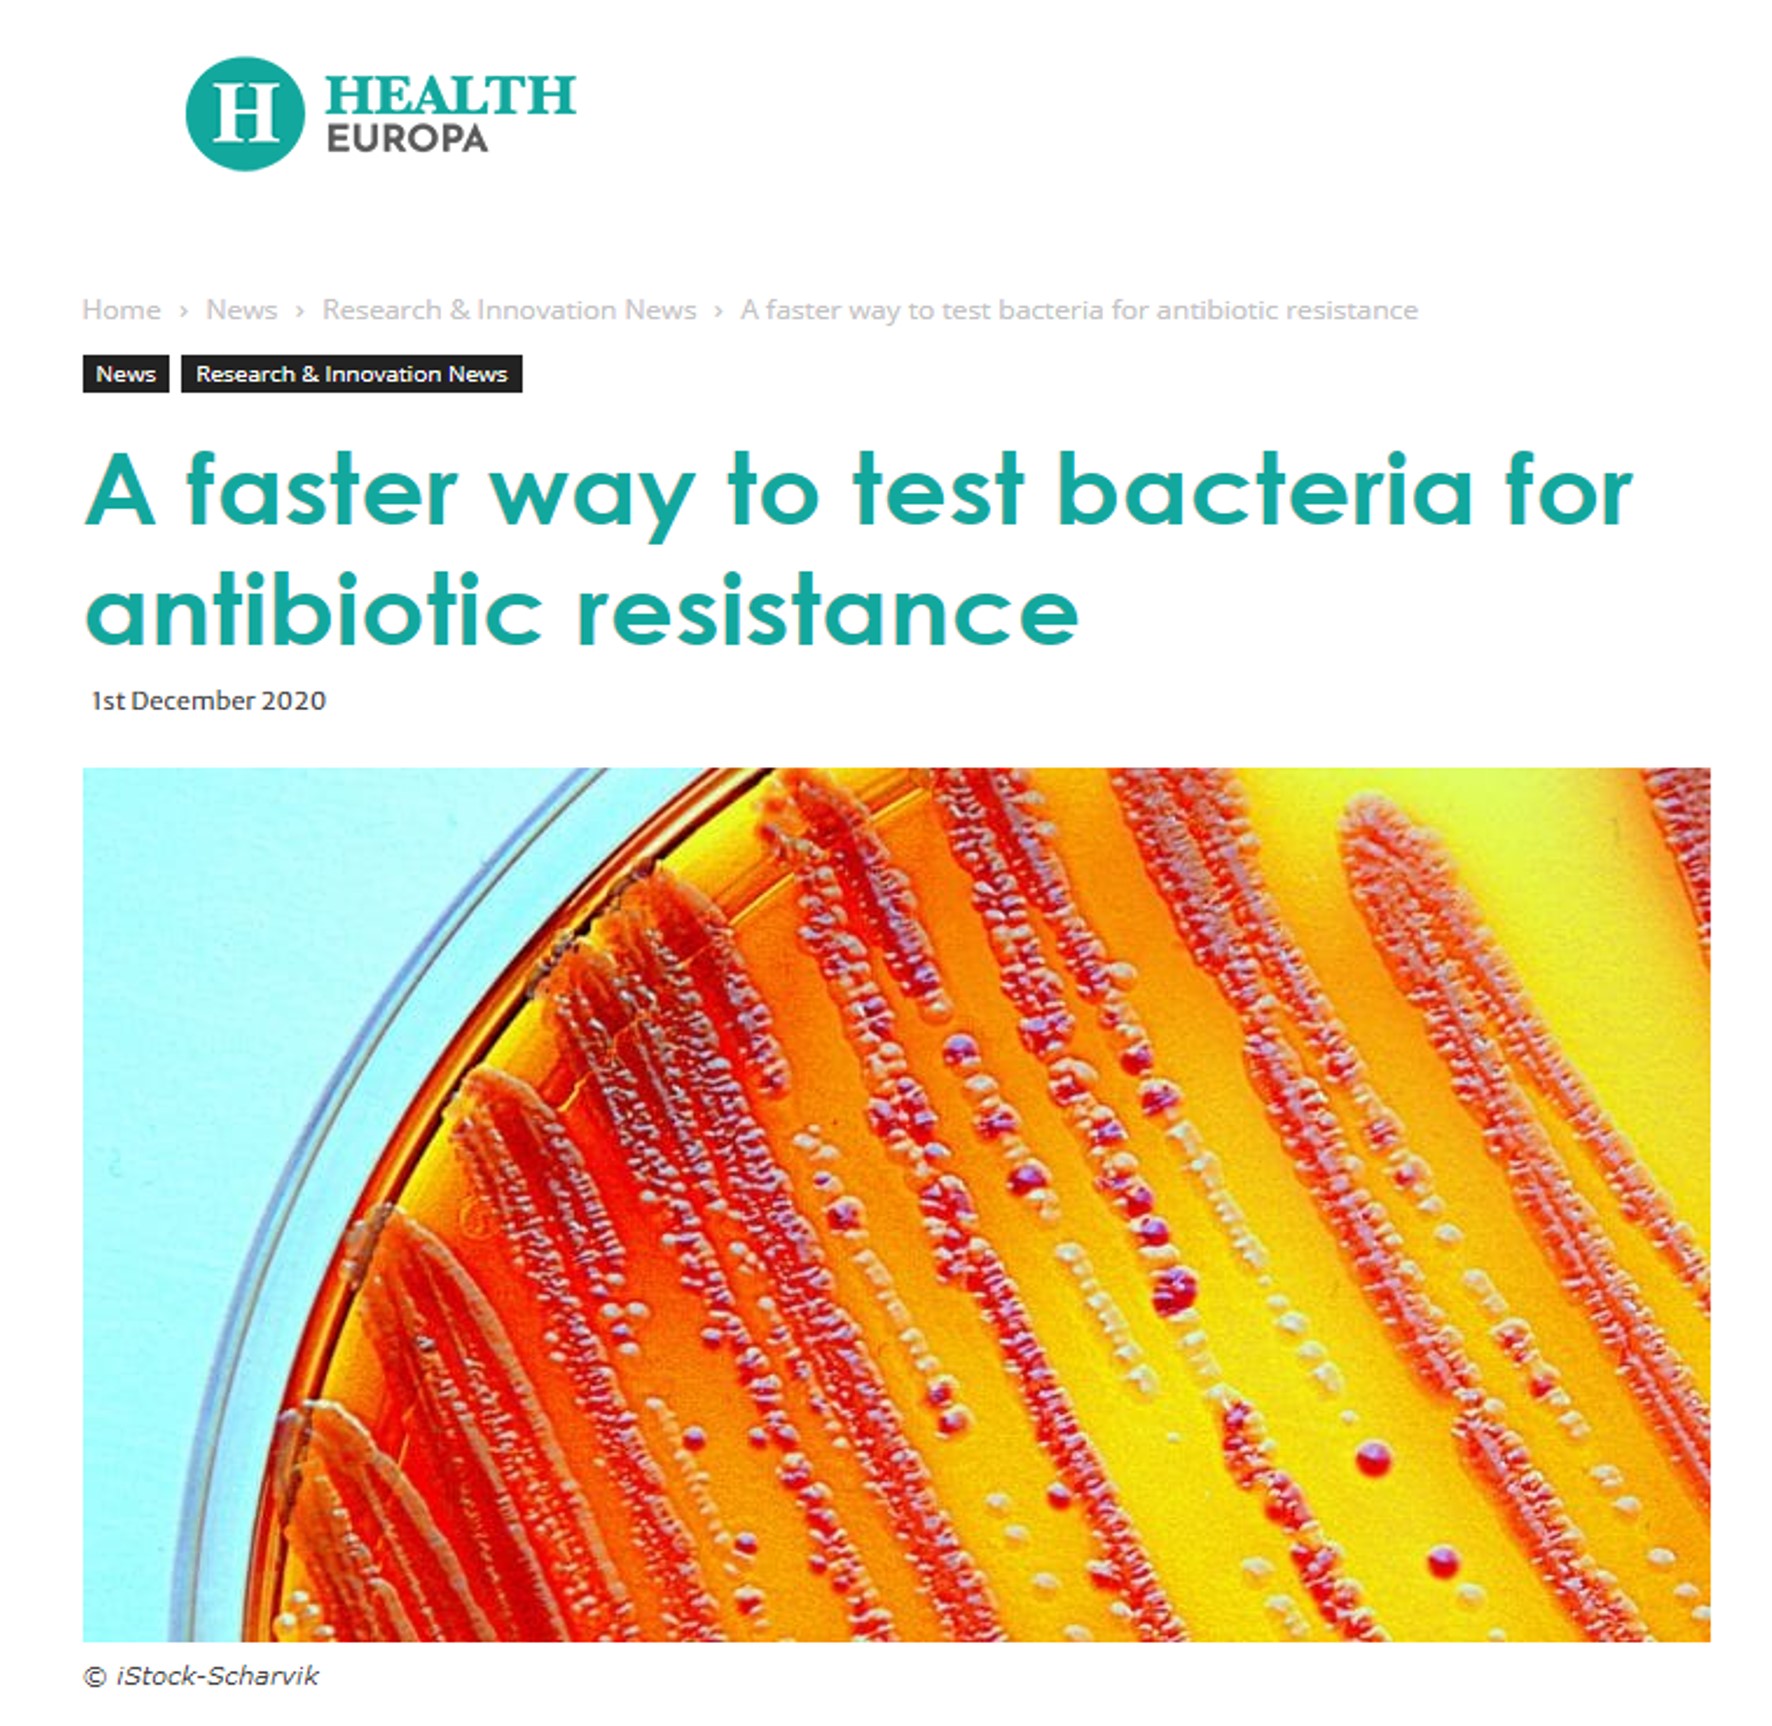

2020. 12. 1 - Many news agencies highlighted our new method for antibiotic susceptibility testing, published in Biosensors and Bioelectronics. The media outlets include Phy.org, Eurekalert, Technologynetworks, Health Europa, and many others.
2020 Lab News
2020 News
2020. 11. 23 - Our article, "Horizontally structured microbial fuel cells in yarns and woven fabrics for wearable bioenergy harvesting," has been accepted by Journal of Power Sources (IF 8.2).

2020. 11. 9 - Our article, "Characterization of Electrogenic Gut Bacteria," has been accepted by ACS Omega (IF 2.9). Our work is featured on the front cover.

2020. 10. 14 - Our article, "PEDOT:PSS/MnO2/CNT Ternary Nanocomposite anodes for supercapacitive energy storage in Cyanobacterial biophotovoltaics," has been accepted by ACS Applied Energy Materials (IF 4.5)

2020. 8. 20 - Our article, "A simple, inexpensive, and rapid method to assess antibiotic effectiveness against exoelectrogenic bacteria," has been accepted by Biosensors and Bioelectronics (IF 10.3)

2020. 8. 12 - Our article, "A disposable, papertronic three-electrode potentiostat for monitoring bacteria electrochemical activity," has been accepted by ACS Omega (IF 2.9). Our work is featured on the front cover.

2020. 8. 10 - Three conference papers for Hilton Head 2020 Workshop have been published in Journal of Microelectromechanical Systems as special proceedings.
2020. 7. 22 - The last moment with Mehdi, Maedeh, and Yang! Group photo!

2020. 7. 10 - Mehdi has passed his Ph.D. Dissertation Defense and has secured a Adjunct Professor position from the University of Texas - Permian Basin. Congratulations!
2020. 7. 1 - Dr. Choi received the SUNY Chancellor's Award for Excellence in Scholarship and Creative Activities.

2020. 6. 20 - Dr. Choi is invited to give an online talk at Temple University (ECE Dept.), Dec. 2nd, 2020.
2020. 6. 20 - Yang Gao has secured a Postdoc position from the University of Texas at Austin.

2020. 6. 1 - Our article, "A portable papertronic sensing system for rapid, high-throughput, and visual screening of bacterial electrogenicity" has been accepted by Biosensors and Bioelectronics (IF 9.5)

2020. 5. 21 - Prof. Choi received a grant ($345k) from the National Science Foundation (NSF) as a co-PI on stretchable papertronics.
2020. 5. 21 - Our article, "Biopower-on-skin: Electricity generation from sweat-eating bacteria for self-powered e-skins," has been accepted by Nano Energy (IF 15.5).

2020. 5. 21 - Our article, "A portable, disposable, paper-based microbial fuel cell sensor utilizing freeze-dried bacteria for in-situ water quality monitoring," has been accepted by ACS Omega (IF 2.6)

2020. 5. 21 - Many news agencies highlighted our work on co-cultured biosolar cells for IoT, published in Nano Energy.
2020. 5. 18 - Dr. Choi serves as a Guest Editor for special issue "Micro- and Nano-scale Sensors and Sensorial Systems in Bioengineering and Biotechnology," in Frontiers in Bioengineering and Biotechnology.
2020. 4. 28 - Our article, "A 96-well high-throughput, rapid-screening platform of extracellular electron transfer in microbial fuel cells" has been accepted by Biosensors and Bioelectronics (IF 9.5)

2020. 5. 1 - Maedeh has secured a tenure-track assistant professor position from the University of Texas - Permian Basin. Congratulations!

2020. 4. 27 - Our article, "A scalable yarn-based biobattery for biochemical energy harvesting in smart textiles" has been accepted by Nano Energy (IF 15.5).

2020. 4. 3 - Yang has passed his Ph.D. Dissertation Defense!
2020. 3. 30 - Jonghyun has passed his M.S. Thesis Defense!
2020. 3. 16 - Maedeh has passed her Ph.D. Dissertation Defense!
2020. 3. 2 - Our article, "A miniaturized, self-sustaining, and integrable bio-solar power system" has been accepted by Nano Energy (IF 15.5).

2020. 2. 12 - Our article, "Paper Robotics: Self-folding, Gripping, & Locomotion" has been accepted by Advanced Materials Technologies and will be highlighted on their news website Advanced Science News and appeared in Hot Topics: Robotics.

2020. 2. 11 - Three papers have been accepted for oral/poster presentations at Hilton Head Workshop.
2020. 1. 23 - We made five research presentations at IEEE MEMS 2020.

2020. 1. 15 - Our article, "Paper-supported High-throughput 3-D culturing, trapping, and monitoring of C. Elegans," has been accepted by Micromachines (Special Issue: 10th Anniversary of Micromachines).